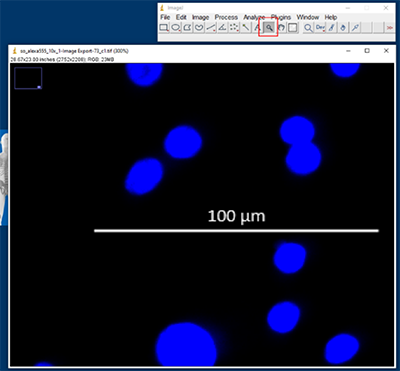

Quantifying Primary Human Hepatocyte Plating Density
TruVivo™, the first and only all-human 2D+ hepatic system, includes endothelial and stromal feeder cells with primary human hepatocytes (PHHs). This physiologically relevant triculture system mimics the microarchitecture and functionality of the human liver over long-term culture, offers reliable results, and is easy to use. This combination of attributes makes TruVivo a promising alternative method for preclinical drug development.
Accurate quantification of plated PHHs in culture is essential to ensure the consistency and accuracy of results. Therefore, LifeNet Health LifeSciences developed a novel method – which has been validated to ensure specificity, accuracy, repeatability, precision, and robustness - for quantifying the PHH plating density for every lot, providing users with confidence during their chemical screening analysis. The PHH plating density for each lot is reported on its respective Certificate of Analysis for data normalization. Our process is outlined below:
Step 1. First, we stain cells with DAPI and CK18 (epithelial cytoskeleton protein marker,
Abcam[ab24561]) at 14 days in culture and capture images. The graphics below show the respective
locations where images are taken within the wells of both 96- and 24-well plate formats.

Step 2. Next, we quantify the cells using ImageJ 1.52a software1 according to the following process.
The scale is set in ImageJ based on the microscope scale bar,
then we size the image accordingly.
Image conversion and threshold are completed. This pixelates the images
to highlight cells and eliminate grainy areas.
The watershed feature is used to delineate individual cells into patches,
then we analyze particles to count DAPI particles and scale images.
Feeder cells are counted by counting the non-CK18 stained particles.
Step 3. Finally, we use the counts determined in Step 2 to calculate the PHH plating density and PHH plateability using the following formula:
PHH Plating Density = (DAPI count - Feeder Cell count) x Scaling Factor*
PHH Plateability (%) = (PHH Plating Density/PHH Seeding Density**) x 100
*Scaling Factor is calculated by the size of the well in the 96- or 24-well plate.
**Seeding density ranges from 150,000 to 300,000 cells/well for 24-well format and from 20,000 to 30,000 cells/well for 96-well format. Refer to lot-specific CoA for recommended optimal seeding density.
References
1 Rasband, W.S., ImageJ, U. S. National Institutes of Health, Bethesda, Maryland, USA, https://imagej.nih.gov/ij/, 1997-2018.
